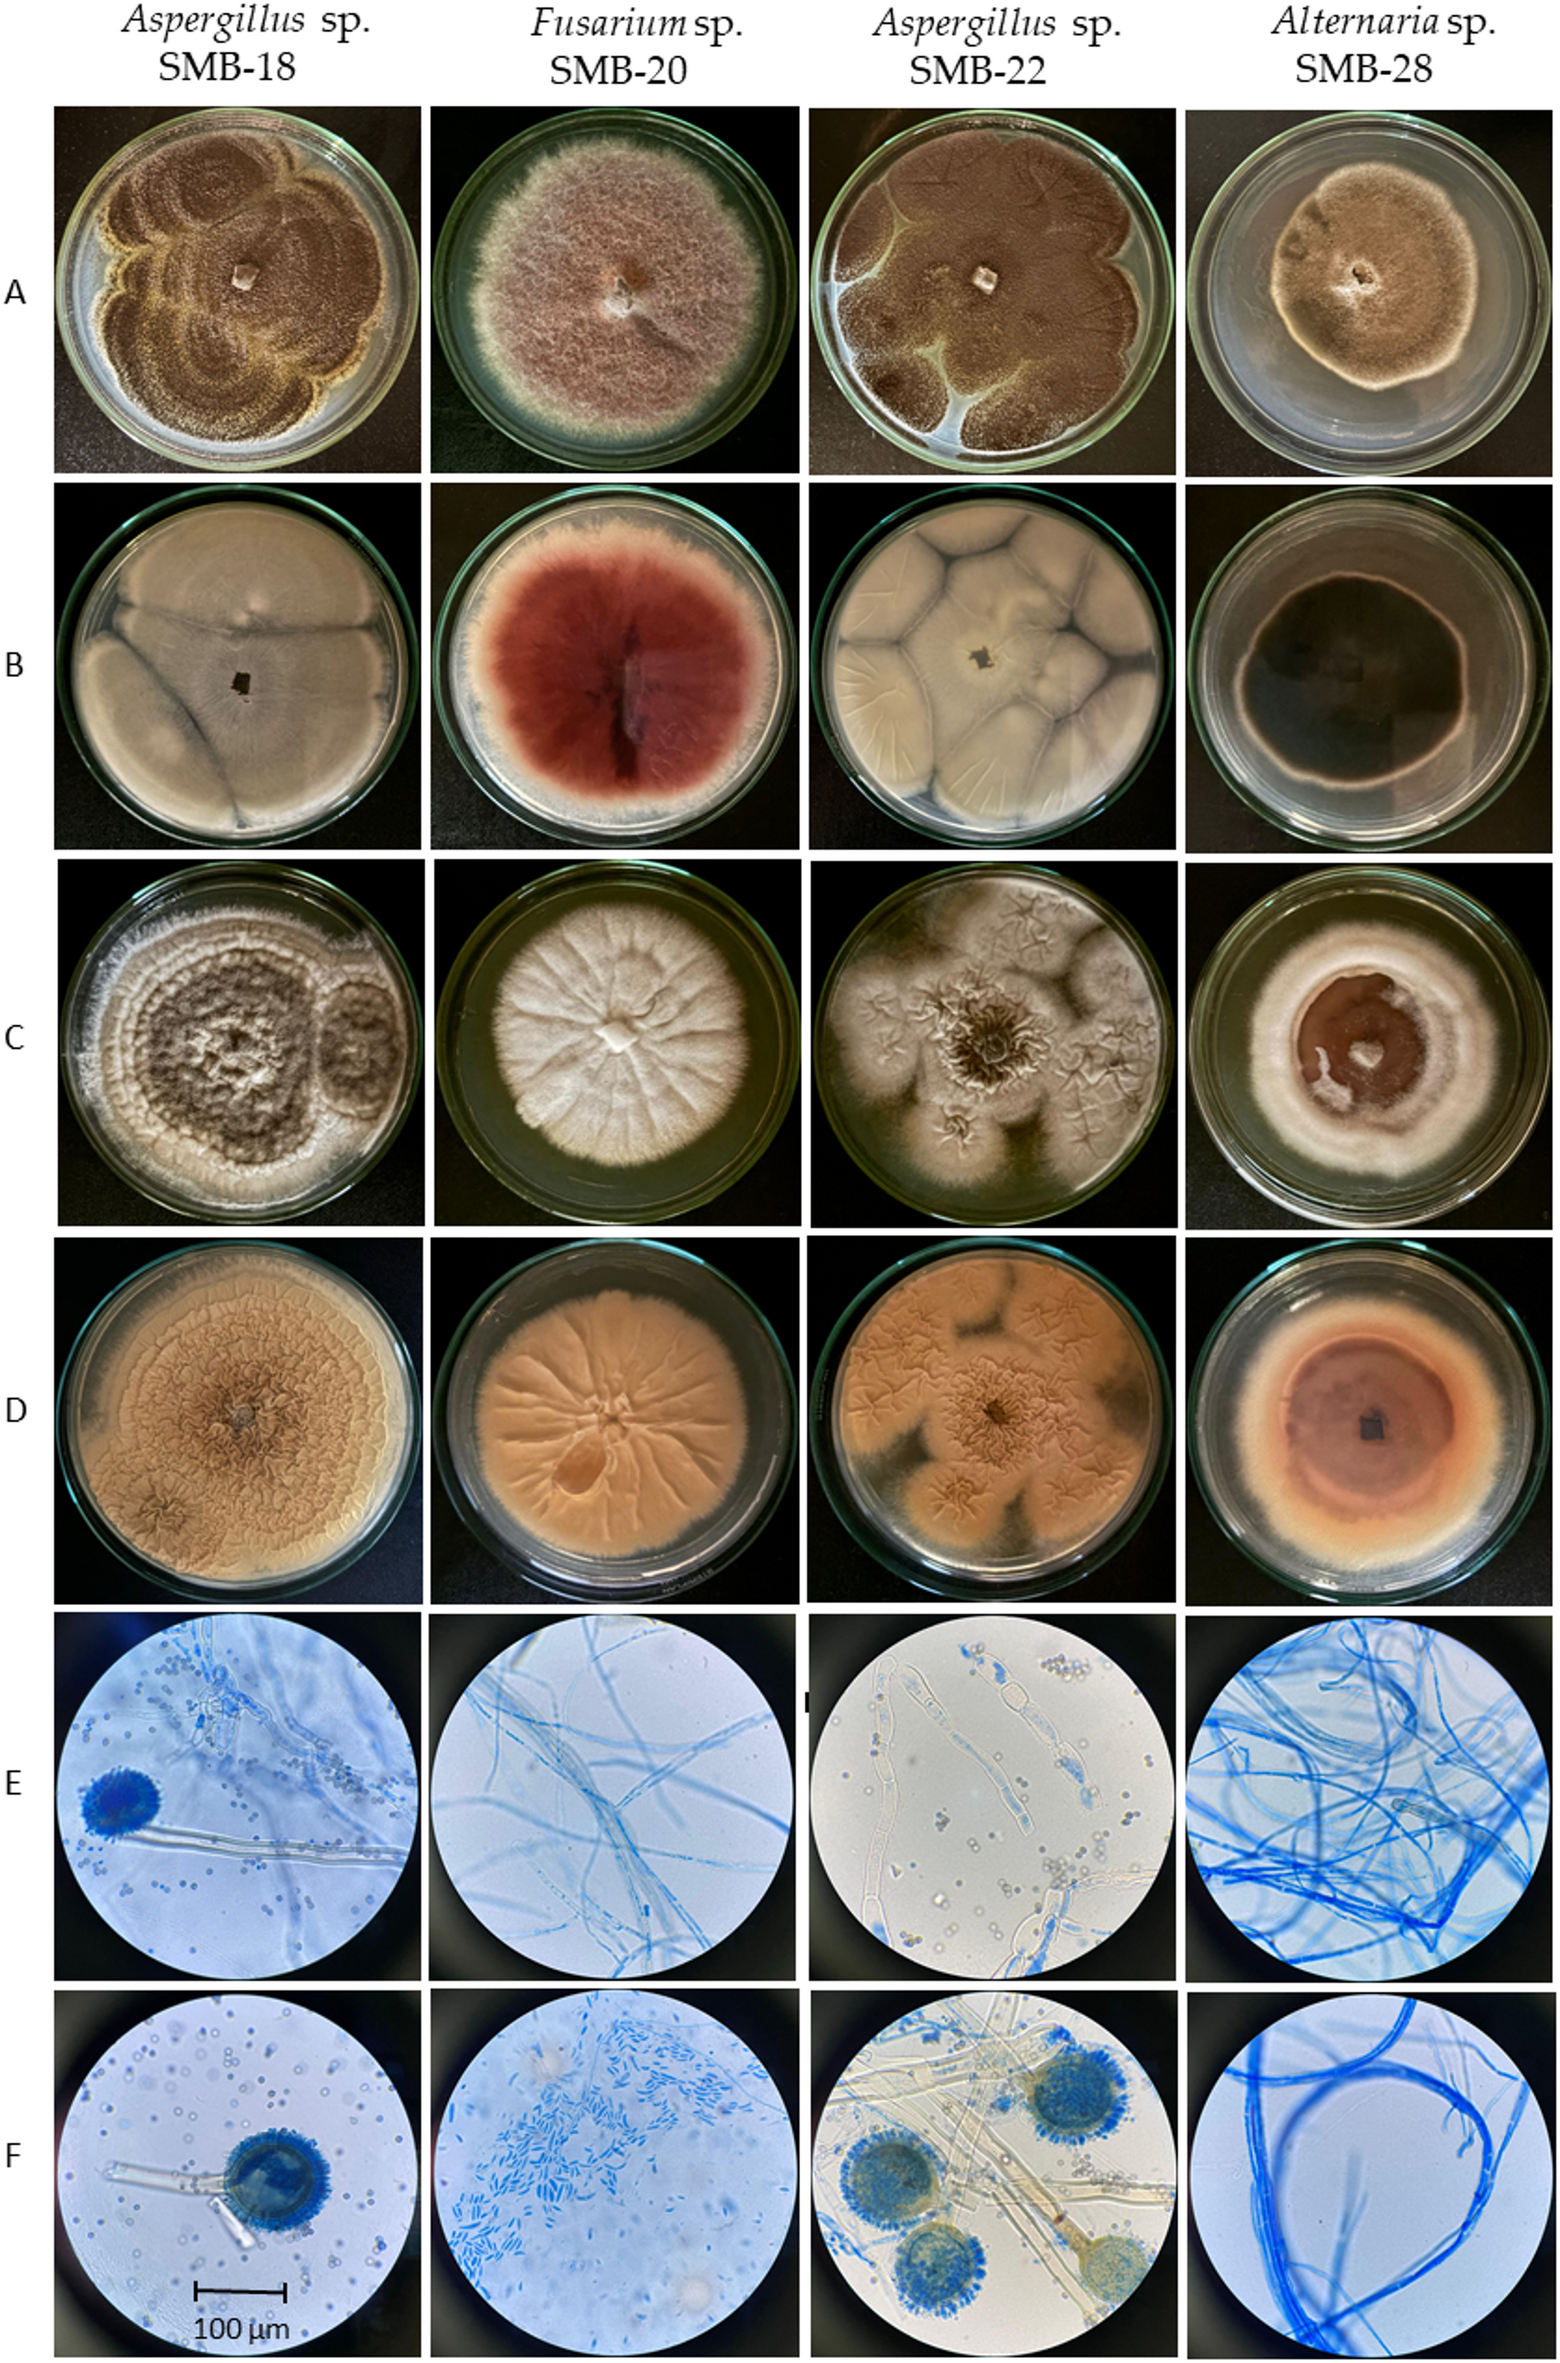
Fig. 6

Fig. 6
Macro- and micromorphological characteristics of endophytic fungi: Colonies on PDA upper (A) and reverse side (B) after 7 days at 30 °C. Colonies on YES upper (C) and reverse side (D) after 7 days at 30 °C. Generative hyphae and mycelium (E) and conidiophores and conidia (F). Samples stained with Lactophenol blue, observed under an LRI-Olympus microscope at 100×/0.65 magnification, and a scale of 1:200.